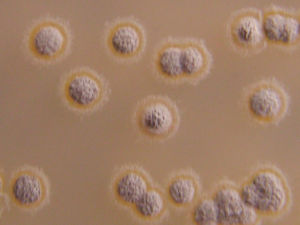
假委內瑞拉鏈黴菌 假委內瑞拉鏈黴菌

基本信息
中文學名:假委內瑞拉鏈黴菌
拉丁學名:Streptomyces(Act.)pseudovenezuelae
參考文獻:Intern.J.Syst.Bactertol.18:362-364,1968.
形態特徵
孢子絲長而直。孢子橢圓形至柱形,表面光滑。
性狀特徵
甘油天冬素瓊脂(ISP)、無機鹽澱粉瓊脂(ISP)、酵母精麥芽精瓊脂(ISP)、燕麥粉瓊脂(ISP):氣絲灰黃粉色,特別在第一種培養基上灰色或白色。基內菌絲體無鑑別色素:淺灰黃色至橙黃色或淺黃褐色。可溶色素無或跡量灰黃色。色素不隨pH而變化。產生類黑色素、酪氨酸酶和H2S。利用D-葡萄糖、L-阿拉伯糖、D-木糖、D-果糖、蔗糖、鼠李糖、棉子糖、肌醇、D-甘露醇。
形態描述
孢子絲長而直。孢子橢圓形至柱形,表面光滑。
討論
代表菌株:USSRRIA-742=IMRU3774=ISP5212。
盤點世界上的微生物(十一)
| 微生物是包括細菌、病毒、真菌以及一些小型的原生動物、顯微藻類等在內的一大類生物群體,它個體微小,卻與人類生活關係密切。涵蓋了有益有害的眾多種類,廣泛涉及健康、食品、醫藥、工農業、環保等諸多領域。 |